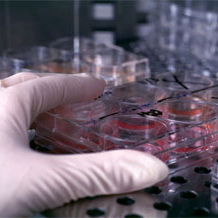

Борис Петриковский, главный научный сотрудник компании по уходу за кожей Beillis Development, обсуждал свои исследования о свойствах эмбриональной кожи и как она может предоставить новые возможности для антивозрастной продукции. Согласно Петриковскому, эмбриональная кожа абсолютно по-другому рубцуется, нежели кожа взрослого человека и вызывает некие сходства с классическим методом заживления ран, которые обычно использовали учёные. «Кожа взрослого человека заживает посредством Для Петриковского, одним из главных отличий между эмбриональной и зрелой кожей является тот факт, что эмбриональная кожа заживает без шрамов. Петриковский говорит, что морщина – это маленький шрам, ответ на травму, и в течение длительного периода времени исследователи были сфокусированы на улучшении способа заживления мелких ран на коже. Именно поэтому он искал методы, которые активируют взрослые стволовые клетки, чтобы они могли действовать также как и эмбриональные. Одним веществом, которое он нашёл, является Peptide 199, цепь из аминокислот, извлечённая из Wharton Jelly, желатиновой субстанции, найдено в пуповине. На вопрос о безопасности этого вещества, Петриковский ответил, что оно является абсолютно безопасным. Активность стволовых клеток не подвергает здоровье риску и не стимулирует развитие раковых клеток. Источник: Новые разработки на Cosmomir.ru | |
Похожие новости:
Народное мнение!!!
Последние новости
| |||
| |
| |
| Имеете ли Вы отношение к косметическому бизнесу? |
2024-04-10 17:27:05
Объем экспорта косметики из Южной Кореи установил новый рекорд
2024-04-10 17:18:19
Серена Уильямс запускает свой косметический бренд
2024-04-10 17:11:49
Яна Рудковская сообщила о запуске собственного бренда косметики
2023-12-24 18:28:20
Лионель Месси представит собственный аромат
2023-12-06 11:41:56
Исследование показало, что психосоциальный стресс может быть провоцирующим фактором для обострения акне
2023-11-29 12:47:39
Ароматы из воздуха
2023-11-15 21:50:17
Основные тенденции развития средств по уходу за телом
2023-11-15 21:38:03
6 главных трендов по уходу за телом в 2023 году
2023-11-15 21:32:50
Потребители вправе вернуть даже невозвратные товары
2023-11-15 18:03:16
Певица Адель запускает свой бьюти-бренд
| |||||||||||||||||||||
| ||

 На заседании под руководством Эрика Перье из LVMH, учёные обсуждали потенциал на косметическом рынке новых исследований о технологии стволовых клеток. Для Перье эта и другие новые сферы исследования акцентируют внимание на том, что продукция по уходу за кожей теперь является не «надеждой в банке», а «эффективностью в банке».
На заседании под руководством Эрика Перье из LVMH, учёные обсуждали потенциал на косметическом рынке новых исследований о технологии стволовых клеток. Для Перье эта и другие новые сферы исследования акцентируют внимание на том, что продукция по уходу за кожей теперь является не «надеждой в банке», а «эффективностью в банке». воспалительной реакции, активируя микрофаги и коллаген 1 типа», объяснил Петриковский.
воспалительной реакции, активируя микрофаги и коллаген 1 типа», объяснил Петриковский. 









